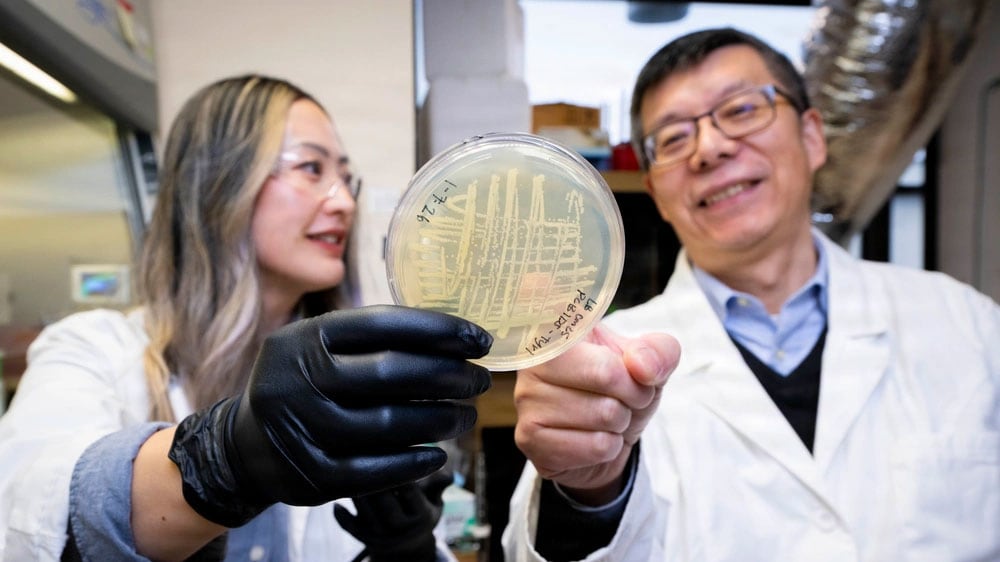
Tiffany Hennessa and Zheng Wang look at petri dish containing bacterial culture

Upward Volume 9, Issue 1 Available Now
In this issue’s cover story, discover how a biotech startup is using space to manufacture artificial retinas that could restore vision in people with macular degeneration. Other features highlight a new in-orbit capture system that could help remove space debris and a study on how microbes could be used to produce valuable materials on long-duration spaceflight missions.
Search across all Upward issues by specific topic, volume, or key word.